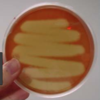
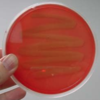
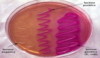

General- Bacteria Images Flashcards
(7 cards)
1
Q
What does this plate show?

A
Alpha hemolysis
2
Q
What does this plate show?
A
Beta hemolysis
3
Q
What does this plate show?
A
Gamma hemolysis
4
Q
What type of medium is this?
Name organisms that would appear pink.
A
McConkey agar;
Lactose fermenters
1) Klebsiella
2) Serratia
3) Enterobacter
4) E. coli
5
Q
Name the finding and causal infection

A
Bubo; Yersinia pestis
6
Q
Name the finding and causal infection

A
Black eschar; Bacillus anthracis
7
Q
Name the finding and causal infection

A
Hemorrhagic mediatinitis due to Woolsorter’s disease; Bacillus anthracis


